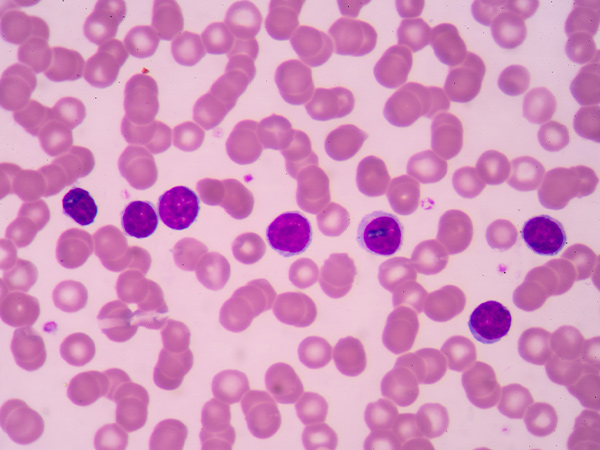

Molecularly Targeted Therapeutic Approved for Another Type of Non-Hodgkin Lymphoma
The U.S. Food and Drug Administration action means ibrutinib is now an approved treatment for three types of non-Hodgkin lymphoma and chronic lymphocytic leukemia.
Use of the molecularly targeted therapeutic ibrutinib (Imbruvica) was recently expanded by the U.S. Food and Drug Administration (FDA) to include a type of non-Hodgkin lymphoma called marginal zone lymphoma.
Ibrutinib is intended for treating patients with marginal zone lymphoma that has progressed despite treatment with at least one CD20-targeted therapeutic. Marginal zone lymphoma is an indolent type of non-Hodgkin lymphoma that arises in immune cells called B cells in a part of lymph system called the marginal zone.
According to the National Cancer Institute, there were an estimated 72,580 new cases of non-Hodgkin lymphoma diagnosed in the United States in 2016 and 20,150 deaths from the disease.
Non-Hodgkin lymphoma is a diverse group of cancers that arise in the lymph system, which is part of the body’s immune system. These cancers can be divided into those that are indolent – meaning they tend to grow and spread slowly, and they have few symptoms – and those that are aggressive – meaning they tend to grow and spread quickly, and they have symptoms that can be severe.
The rationale for testing ibrutinib as a potential treatment for marginal zone lymphoma stems from the fact that ibrutinib targets the protein Bruton agammaglobulinemia tyrosine kinase (BTK), which is a component of a signaling pathway that promotes the survival and expansion of normal and marginal zone lymphoma B cells.
The approval of ibrutinib to treat marginal zone lymphoma was based on results from the PCYC-1121 phase II clinical trial, which were presented at a scientific meeting in December 2016. In brief, they show that 46 percent of patients treated with ibrutinib had significant tumor shrinkage, with 3.2 percent having complete tumor shrinkage and 42.9 percent having partial shrinkage. At the time the data were presented, the median duration of response had not been reached.
Given that the approval centered on response data, rather than overall survival, the companies jointly developing ibrutinib, Janssen Biotech Inc. and Pharmacyclics LLC, are required by the FDA to conduct a study to confirm that the drug improves survival for patients.
With this decision, ibrutinib is now approved for treating three types of non-Hodgkin lymphoma – marginal zone lymphoma, mantle cell lymphoma, and Waldenström macroglobulinemia – as well as chronic lymphocytic leukemia (CLL), including CLL that harbors a 17p deletion.
The FDA approval was rendered on Jan. 18, 2017.